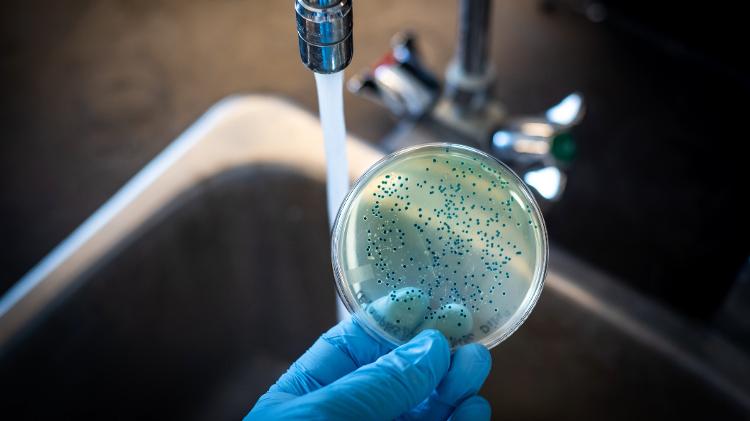

Nosso corpo é constituído de cerca de 70% de água. Não à toa, esse líquido é fundamental para a nossa vida e para o bom funcionamento do organismo.
Mesmo assim, ainda hoje, um quarto da população mundial não tem acesso à água potável, de acordo com (]*rel=”)noopener(“[^>]*>)dados da OMS (Organização Mundial da Saúde).
O problema é um desafio no Brasil, que ainda derrapa nesse quesito em pleno século 21. Segundo o SNIS (Sistema Nacional de Informações sobre Saneamento), quase metade da população do país (cerca de 100 milhões de pessoas) não tem acesso ao saneamento básico —isto é, sistema de esgoto e/ou de água tratada.
“Geralmente, essas pessoas residem em áreas afastadas que não possuem infraestrutura necessária para receber água pelas concessionárias”, afirma Fernando Silva, CEO da PWTech, startup que oferece soluções para oferecer água potável em regiões carentes.
É um cenário desolador e de alta insegurança para a saúde dessas pessoas, que estão mais vulneráveis a contraírem infecções —entre elas, algumas consideradas graves, como a cólera.
“Muitas das doenças associadas à água e alimentos contaminados são causadas por patógenos transmitidos via fecal-oral, um processo facilitado pela falta de tratamento adequado dos esgotos sanitários“, afirma Clarissa Barros Madruga, médica infectologista da Clínica de Doenças Infecciosas e Parasitárias do HULW-UFPB (Hospital Universitário Lauro Wanderley, da Universidade Federal da Paraíba) e professora da mesma instituição.
Como essas doenças se espalham?
A água contaminada pode provocar doenças de três formas: ao ser ingerida, ao ser usada para preparar alimentos ou ainda quando a pessoa entra em lagos, rios e mar que estejam contaminados.
Vírus, bactérias e parasitas são os agentes mais comuns causadores de doenças via água contaminada. No geral, esses problemas têm como sintomas diarreia, náuseas e vômitos, uma tríade em comum. Dores abdominais, febre e sonolência também podem estar presentes.
A própria OMS estima que cerca de 829 mil pessoas morrem todos os anos de diarreia causada pela ingestão de água contaminada. O problema afeta especialmente as crianças, que costumam ficar desidratadas rapidamente após quadros de infecção.
Além de micro-organismos patogênicos, a água contaminada pode carregar toxinas e substâncias químicas que causam intoxicação no ser humano, acrescenta Igor Brandão, médico infectologista do Hospital da Bahia, da rede Dasa.
Quais são as doenças mais comuns?
Como dissemos, a água contaminada pode gerar problemas tanto se você beber como se usá-la para preparar alimento. Nesse caso, a água facilita a disseminação das DTAs (doenças transmitidas por alimentos), consideradas problema de saúde pública no mundo todo.
Atualmente, existem mais de 250 doenças conhecidas que são transmitidas via alimentos e água contaminada. A maioria provoca sintomas incômodos, mas leves e autolimitados —ou seja, se resolvem sozinhos após cerca de cinco dias.
Outras, no entanto, podem provocar quadros mais graves e debilitantes e até levar à morte.
Disenteria bacteriana
A disenteria é uma inflamação do intestino grosso que causa sintomas como náuseas, vômitos, diarreia e febre. As fezes podem ainda conter muco e sangue.
Nesse caso, o principal vetor são as bactérias presentes na água contaminada. As mais comuns são Shigella, Salmonella, Campylobacter, Escherichia coli e Yersinia (esta última, causadora da peste bubônica).
Cólera
A cólera é provocada pela toxina da bactéria Vibrio cholerae, encontrada em água não tratada.
O principal sintoma é a grande quantidade de diarreia aquosa que, se não for tratada logo, pode levar a um quadro grave de desidratação que coloca em risco a vida do paciente —especialmente crianças e idosos.
“É uma gastroenterite com alto potencial de levar a pessoa à morte e, sem um sistema eficiente de tratamento de águas, sempre há a possibilidade de novos surtos”, lamenta Madruga.
Parasitoses intestinais
São doenças causadas por parasitas (comumente chamados de “vermes”), que se instalam no intestino grosso ou delgado, provocando uma infecção que gera dores abdominais, cólicas, vômitos e diarreia.
Estão nessa categoria a amebíase; a giardíase (causada pelo protozoário giárdia); a ascaridíase (causada pelo Ascaris lumbricoides, comumente conhecido como lombriga); e a estrongiloidíase.
Hepatite A
A doença é transmitida por vírus que pode contaminar mananciais de água doce e ainda regiões de água salgada. “O vírus pode até mesmo sobreviver ao congelamento, por isso é preciso ter cuidado com cubos de gelo acrescentados às bebidas”, alerta a infectologista Clarissa Madruga.
A hepatite afeta o fígado, que inflama e pode gerar icterícia (olhos e pele amarelados), dor abdominal, vômitos, náuseas e mal-estar.
Vale lembrar que existe vacina contra a hepatite A disponível no SUS. Ela está no calendário nacional de imunização infantil.
Toxoplasmose
Doença provocada pelo Toxoplasma gondii, que pode ser eliminado pelas fezes de gatos. Mas os felinos são os menos culpados nessa história: a forma mais comum de contágio é pelo contato direto com as fezes contaminadas, pela ingestão de água contaminada ou o consumo de alimentos higienizados com água não tratada, em que o parasita esteja presente.
A doença provoca dor de cabeça e no corpo, febre e mal-estar.
O grande perigo é para as grávidas, já que há risco de má -ormação fetal.
Como é o tratamento?
Felizmente, a maioria dessas doenças evolui de forma leve a moderada. Assim, o principal cuidado é manter o corpo hidratado com a ingestão de líquidos, fazer refeições leves (evitando alimentos gordurosos, com muita fibra ou lácteos); e ainda usar medicamentos de suporte (como analgésicos e remédios para o controle de náuseas e vômitos).
No entanto, em casos mais graves, é necessário o uso de antibióticos e até internação. Por isso, febre e diarreia persistentes por mais de 48 horas são sinais de que é preciso buscar ajuda médica.
Como evitar a contaminação?
O principal é evitar o uso de água contaminada tanto para o consumo como para a higienização das mãos, escovação de dentes e higienização ou preparo de alimentos e bebidas (sucos, por exemplo).
Para isso, utilize água mineral ou filtrada sempre que for realizar essas atividades. Se não for possível, pode-se ferver a água e ainda adicionar uma solução de hipoclorito de sódio a 2,5%.
Fonte: uol
Colunista: @chefcarlosmiranda